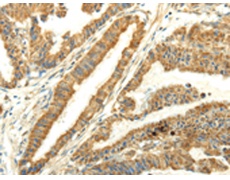
一抗

中文名稱: 兔抗UBL4B多克隆抗體
|
Background: |
Ubiquitin is a 77 amino acid protein that targets proteins for degradation by the 26S proteasome. Ubiquitin-like proteins are not directly involved in protein degradation, but appear to have many mechanistic similarities with the ubiquitin pathway. UBL4B (Ubiquitin-like protein 4B) is a 174 amino acid cytoplasmic protein that contains a ubiquitin-like domain. UBL4B likely arose by retroposition during mammalian evolution from UBL4A, an X-linked intron-bearing housekeeping gene. While UBL4A is highly conserved, UBL4B has undergone rapid evolution and may have evolved new functions. Expression of UBL4B is restricted to post-meiotic germ cells in testis and ovarian tissue, where it likely functions in post-translational protein modification. |
|
Applications: |
ELISA, IHC |
|
Name of antibody: |
UBL4B |
|
Immunogen: |
Full length fusion protein |
|
Full name: |
ubiquitin-like 4B |
|
SwissProt: |
Q8N7F7 |
|
ELISA Recommended dilution: |
2000-5000 |
|
IHC positive control: |
Human esophagus cancer and human liver cancer |
|
IHC Recommend dilution: |
25-100 |

 購物車
購物車 幫助
幫助
 021-54845833/15800441009
021-54845833/15800441009